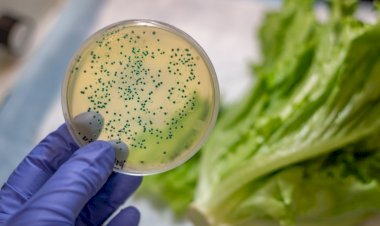
Alimentos contaminados podem causar doenças diarreicas e levar a quadros de desidratação

Este site utiliza cookies. Ao continuar a navegar no site, você concorda com o uso de cookies
Tag: Segeam
Segeam lança projeto ‘Sorriso Top’ com foco na saúde bucal...
A cerimônia contou com apresentações musicais, de dança e atividades recreativas, prestigiadas por pais e alunos da unidade de ensino
Dia Mundial de Combate ao Suicídio: abordar o tema ajuda...
São 800 mil mortes por essa causa ao ano, um número para refletir e derrubar a tese de que ‘falar sobre o tema, pode estimular a prática’.
Anticorpos contra a Covid-19 podem ser transferidos aos...
O ideal é que o bebê seja alimentado até os seis meses, exclusivamente, com o leite materno, prática que dispensa, inclusive, a ingestão...
Segeam e Berkeley trazem a Manaus cursos de suporte à vida...
As atividades ocorreram entre os dias 15 e 24 de julho, na sede da Associação, no bairro Parque Dez, zona Centro-Sul de Manaus
’Infecção cruzada’ em ambiente hospitalar pode ser evitada...
Estudos recentes apontam que esse tipo de situação ocorre com uma frequência de 13?4,3?ntro das unidades de saúde
Evento virtual no Amazonas atraiu 2 mil pessoas para atualização...
As apresentações foram feitas pelas enfermeiras Larissa de Almeida, mestranda pela Universidade Federal do Amazonas (Ufam), e Regiane...
Segeam amplia programação da sua ‘Semana da Enfermagem’,...
O cronograma, que seria encerrado no último dia 20, seguirá até o dia 26 de maio
Segeam promove ‘Semana da Enfermagem’ a partir desta segunda-feira,...
A escolha do mês de maio faz alusão ao Dia Internacional da Enfermagem e do Enfermeiro, comemorado no próximo dia 12
Ganho excessivo de peso durante a gravidez aumenta os riscos...
O sobrepeso também eleva as chances de ocorrência de partos cirúrgicos
Segeam inicia processo de Certificação em Excelência em...
Certificação é uma grande aliada, pois auxilia na padronização e instrumentalização da gestão e assistência em enfermagem
Associação de enfermagem lança programa com dicas de saúde...
Os personagens atenderão a critérios técnicos, como formação e especialização nas áreas de abordagem
Alimentos contaminados podem causar doenças diarreicas...
Uma dica importante é criar o hábito de verificar o prazo de validade, no caso de alimentos industrializados
Segeam entrega à SES-AM documentos que desmentem denúncia...
Os pagamentos têm sido efetuados com regularidade, imediatamente após a liberação dos valores pela SES
Associação alerta que produção excessiva de ácido úrico...
A Gota tem início com o acúmulo de ácido úrico no sangue e nos tecidos, levando à formação de cristais que acabam depositados nas...
Pacientes portadores do diabetes participam de atividades...
O diabetes é uma alteração metabólica crônica evidenciada por altos níveis de glicose no sangue durante um longo período